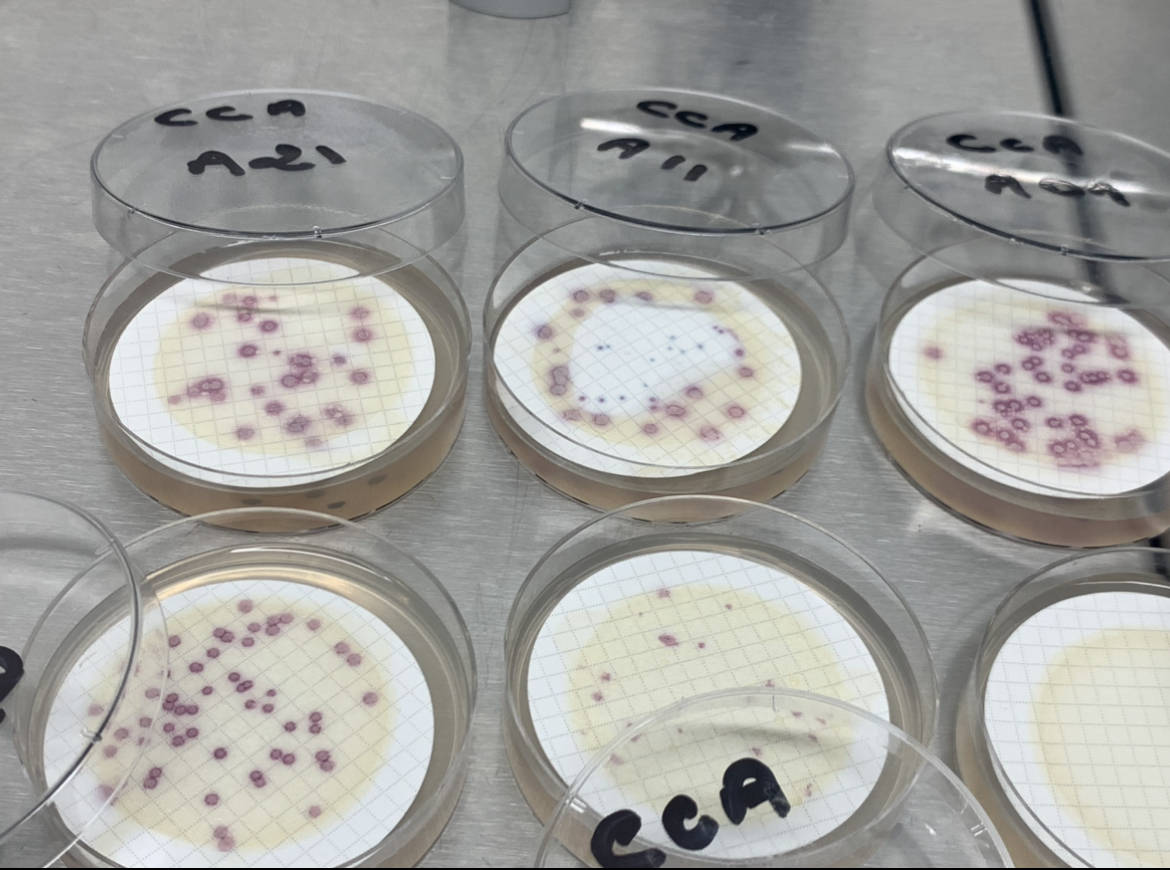

L’Agence régionale de Santé (ARS) de Mayotte a prévenu il y a quelques semaines que l’eau courante à Mayotte est désormais « impropre à la consommation » directement après les coupures. Wirdani Toibibou, directeur du laboratoire EA2S Solutions analytiques à Passamaïnty, est lui très inquiet. D’après lui, la situation est plus grave que ce que laisse transparaître les services en charge de la gestion de l’eau. Il nous a reçus dans son laboratoire pour nous faire part des analyses d’eau qu’il a menées de son côté.
Mayotte s’est habituée aux coupures d’eau toutes les semaines depuis novembre 2022. Celles-ci sont mêmes devenues plus fréquentes à mesure que la sécheresse a gagné l’île. Depuis le 17 juillet, Mamoudzou, Koungou et Petite-Terre ne sont plus alimentées dès la fin d’après-midi. Pour les treize autres communes, les trois coupures durent vingt-quatre heures. Ce système D a simplement le mérite de ralentir la raréfaction d’une ressource dont la qualité commence sérieusement à inquiéter.
L’eau à Mayotte est-elle consommable ?
La qualité de l’eau courante à Mayotte est préoccupante et ce n’est une surprise pour personne sur l’île. Si l’Agence régionale de Santé (ARS) conseille de ne pas consommer l’eau du robinet juste après une coupure, Wirdani Toibibou préconise, lui, de ne pas la boire du tout – peu importe l’heure de la journée. Ce scientifique mène des analyses pour des entreprises privées depuis quatre ans maintenant (secteurs du bâtiment, de l’hôtellerie, de la restauration…). Il est en charge de vérifier le niveau analytique de l’eau et d’avertir le client en cas de problème. Si ses analyses au cours des dernières années étaient relativement normales, il constate un changement alarmiste depuis ces derniers mois. « Depuis que les coupures ont été instaurées, j’ai relevé des taux inquiétants vis-à-vis de la qualité de l’eau », affirme-t-il. « Ces derniers temps, la situation s’est fortement dégradée. On remarque de plus en plus de non-conformité dans nos interventions. On ne sait pas si c’est le réseau qui est trop vétuste pour bien stocker l’eau ou si c’est l’eau en elle-même… Ce qui est sûr c’est qu’il y a constamment des particules qui restent dans les conduites et qui sont directement envoyées vers le consommateur ».
Qu’est-ce qu’on y trouve ?
D’après le scientifique, la présence de certaines bactéries dans l’eau courante est tout à fait inédite à Mayotte. « Il y a une prolifération de la bactérie Escherichia Coli et des bactéries coliformes » (cf. photos). Si ces bactéries sont, la plupart du temps bénignes pour l’homme, certaines souches sont pathogènes et peuvent entraîner des complications médicales. Wardini Toibibou précise ; « Pathogènes ou non, ce qui est certain, c’est qu’il n’est pas normal d’en trouver dans de l’eau provenant des robinets ». L’eau est toujours officiellement potable, mais il soutient qu’il est préférable de ne pas la boire. Les premiers signes qui doivent alerter sont des maux de ventre, des diarrhées, de la fièvre, ou encore la présence de sang dans les selles. A l’apparition de ces signes, il est fortement conseillé de substituer l’eau du robinet par de l’eau en bouteille.
Stocker l’eau, une fausse-bonne idée ?
L’autre grande problématique concerne le stockage. Les cuves de stockage d’eau fleurissent un peu partout sur l’île. Si ces réserves sont des solutions à court terme, elles s’avèrent être en réalité de véritables bombes à retardement d’un point de vue de santé publique. Wirdani Toibibou explique que des milliards de bactéries prolifèrent dans une eau stagnante, d’autant plus lorsque la température est élevée comme elle l’est à Mayotte : « Prenez l’exemple d’un seau, en à peine deux jours, un dépôt se forme en surface. Imaginez donc ce qui se forme dans une cuve de 3.000 litres qui stocke de l’eau pendant plusieurs semaines ». A court terme, il recommande un nettoyage quotidien des cuves nécessaire, voire obligatoire. Celui-ci doit se faire avec des produits désinfectants et de l’eau de javel, afin de tuer les bactéries les plus résistantes.
Comment les autorités encadrent-elles la consommation ?
Tout département français est soumis à un règlement administratif regroupant les règles générales d’hygiène. A Mayotte, le dernier règlement recensant ces normes date de novembre 2019. Le règlement sanitaire départemental (RSD) était alors adapté à une autre situation que celle d’aujourd’hui. Selon Wirdani Toibibou, « il faudrait que les autorités éclaircissent les normes du RSD à Mayotte au sujet de l’eau ». L’interdiction de certains formats de cuves de stockage pourrait être envisagée, entre autres. « La SMAE et l’ARS sont responsables de l’acheminement de l’eau jusqu’au compteur, mais après, c’est aux familles d’entretenir cette eau. Seulement, il faut qu’un encadrement légifère tout ça ». Le scientifique soutient que ces normes sont là pour protéger et non pas pour sanctionner la population.
La vente d’anti-diarrhéiques en augmentation
D’après le dernier rapport de Santé Publique France, datant du 17 août, aucune maladie n’a pour le moment été détectée à la suite d’une consommation de l’eau courante. Cependant, la vente d’anti-diarrhéiques a augmenté, la semaine dernière, et « le taux d’activité pour infections cutanées chez les médecins sentinelles est à un niveau élevé par rapport aux années précédentes ». L’évolution de la situation est surveillée de près par les autorités.